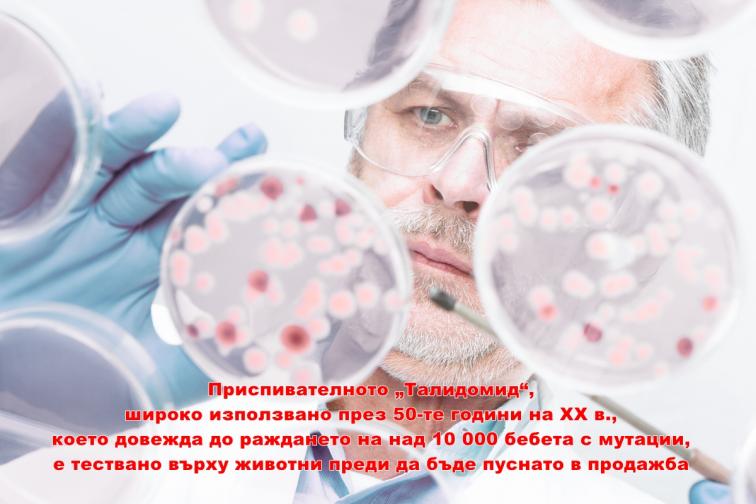

Защо да отглеждаме октоподи във ферми не е добра идея
Любопитно Защо да отглеждаме октоподи във ферми не е добра концепция Те могат да отварят буркани, да разграничават хората, да запомнят пъзели и ядат извънредно доста  31 май 2019, 12:08 .a{fill:#fff;}.b{fill:#676767;}
31 май 2019, 12:08 .a{fill:#fff;}.b{fill:#676767;} 
Защо да отглеждаме октоподи във ферми не е добра концепция

Книгите, които да прочетем през юни

Колко боровинки би трябвало да похапваме дневно и за какво са потребни

Една легенда на 89г. – Клинт Истууд

Тайната на гората в Папуа - плодните прилепи

Ариана Гранде разкрила, че е алергична към доматите

Новолуние в Близнаци - няколко неща, които би трябвало да знаем

Едни от най-красивите градчета в Чехия (СНИМКИ)
е може да се отхвърли, че развъждането на животни има голямо значение за човечеството от милиони години.
За разлика от овцете и кравите обаче, които са пригодени да бъдат отглеждани от хора, има и типове, които не биха процъфтявали във ферми.
В нов отчет учени коментират за какво октоподите не би трябвало да бъдат отглеждани във ферми.
Не единствено тъй като са интелигентни, само че и поради последствията, до които това ще докара.
Световният апетит за октоподи пораства
През миналата година заради огромното търсене и незадоволителния запас цените на октоподите стремително се повишиха. Експерти чакат те да останат високи най-малко до края на 2019 година
Количеството октоподи, уловени в свободни води, варира, което прави ловците на октоподи несигурни източници на скъпия артикул.
Това кара хората да стартират да отглеждат октоподи във ферми и даже да организират опити да развъждат главоноги мекотели посредством генна трансформация.
Учените се притесняват, че развъждането на октоподи ще докара до неизбежни последици за околната среда като азотно и фосфорно замърсяване от скотски боклуци, кръстосване на типове, разпространение на заболявания и дано не забравяме – загуба на естествения хабитат на октоподите.
По тематиката Откриха подводен град на октоподи в Австралия
Откриха подводен град на октоподи в Австралия  Как рибите оцеляват при гръмотевична стихия
Как рибите оцеляват при гръмотевична стихия  Учени предвиждат: до 2048 рибата ще намалее фрапантно
Учени предвиждат: до 2048 рибата ще намалее фрапантно  Колко незнайни на хората същества населяват океаните
Колко незнайни на хората същества населяват океаните
Най-притеснително е храненето на октоподите,
пишат учените в отчета си. Както множеството отглеждани във ферми морски животни, октоподите са месоядни. Това значи, че имат потребност от рибен протеин и рибно масло в диетата си.
Недоразвитите октоподи пък се хранят единствено и само с жива храна, която във фермите би трябвало да им се набира непрекъснато.
Една трета от уловената риба по целия свят се употребява за хранене на други животни. Около половината от тази една трета отива при октоподите във фермите.
Много от типовете риби, които хората на драго сърце употребяват, са обект на свръхриболов и броят им фрапантно понижава.
Октоподите имат потребност от доста храна и засищането на глада им може да докара до понижаване на международните ресурси за човечеството.
Дори и този проблем да бъде позволен обаче, има друга аспект, който прави развъждането на типа във ферми неприятна концепция.
Октоподите са известни със своята просветеност
и умеенето си да позволяват проблеми. Поради тази причина в аквариумите им се оставят разнообразни играчки, с цел да не се отегчават.
Могат да отварят буркани, да разграничават хората, да запомнят пъзели, които към този момент са решавали, и даже да избягат от аквариум, в случай че са прекомерно отегчени.
Представете си какво би се случило, в случай че октоподите от една плантация провеждат „ бягство от пандиза “…
В плен октоподите развиват ексцентрично държание
като канибализъм и хранене от личните си пипала.
„ Освен аспектите за биологичното здраве и сигурността, октоподите имат потребност от високи равнища на когнитивна стимулация, включваща проучване, операция и надзор над заобикалящата среда. Интензивните фермерски системи са неизбежно негостоприемни за тези животни “, написа екипът от учени.
Поради тези и други фактори учените по света се пробват изкуствено да развъждат октоподи.
Опитите за развъждането на октоподи
в Мексико през последното десетилетие са много обещаващи.
През 2017 година японска компания за морски храни заяви за сполучливо изкуствено измътени яйца на октопод и показа упованията си до края на идната година да може да предлага октоподи.
„ Надяваме се, че тези варианти ще стартират да се ползват и обществото ще осъзнае сериозните екологични и здравословни проблеми, до които планове като развъждане на октоподи във ферми могат да доведат “.
Какво не знаем за опитите върху животни



Следете ни на всички места и когато и да е с мобилното приложение на Vesti.bg. Можете да го изтеглите от Гугъл Play и AppStore.
За още настоящи вести от Vesti.bg последвайте страницата ни в Instagram.
 Абонирайте се и прочетете първи " Непубликувано " и преглед на деня за 2 мин. АБОНИРАЙ съдебна експертиза Редактор: Деница Георгиева Източник: октопод плантация учени пирода .comments-item{clear:left;}.article-comment-types div{z-index:100;}.answer { margin-left:33px; } Фонетична БДС Изключена
Абонирайте се и прочетете първи " Непубликувано " и преглед на деня за 2 мин. АБОНИРАЙ съдебна експертиза Редактор: Деница Георгиева Източник: октопод плантация учени пирода .comments-item{clear:left;}.article-comment-types div{z-index:100;}.answer { margin-left:33px; } Фонетична БДС Изключена
* Моля, коментирайте съответната публикация и използвайте кирилица! Не се толерират отзиви с обидно или нецензурно наличие, на верска или етническа основа, както и написани единствено с основни букви!
0 коментара Не пропускай
Далай Лама: Русия би трябвало да влезе в Европейски Съюз

Валери Симеонов: В ГЕРБ оставките са насилствени

Зов за помощ: Да помогнем на Калина да живее

Класираха измежду колите втора употреба
За дома
 Апартамент в Пловдив, който очарова с интериор (СНИМКИ)
Апартамент в Пловдив, който очарова с интериор (СНИМКИ)  Една причина за какво би трябвало да имате свежи цветя в дома.box-CashCredit { margin: 50px 0; }.box-CashCredit img { width: 100%; height: auto; }.box-CashCredit.list-item:nth-child(1) { border-top: 0 none; }.box-CashCredit.box-content { border: 9px solid #316fa0; }
Една причина за какво би трябвало да имате свежи цветя в дома.box-CashCredit { margin: 50px 0; }.box-CashCredit img { width: 100%; height: auto; }.box-CashCredit.list-item:nth-child(1) { border-top: 0 none; }.box-CashCredit.box-content { border: 9px solid #316fa0; } 
 Горите, в които е по-добре да не стъпва човешки крайник (ВИДЕО)
Горите, в които е по-добре да не стъпва човешки крайник (ВИДЕО)  10 неповторими черти, които имат единствено представителите на зодия Близнаци
10 неповторими черти, които имат единствено представителите на зодия Близнаци  Кои храни би трябвало да заобикаляме, в случай че постоянно ни боли глава? (ВИДЕО)
Кои храни би трябвало да заобикаляме, в случай че постоянно ни боли глава? (ВИДЕО)  Имате ли цип на облеклата? Вижте го деликатно, написа ли YKK? --> АКЦЕНТИ
Имате ли цип на облеклата? Вижте го деликатно, написа ли YKK? --> АКЦЕНТИ  Горите, в които е по-добре да не стъпва човешки крайник (ВИДЕО)
Горите, в които е по-добре да не стъпва човешки крайник (ВИДЕО)  10 неповторими черти, които имат единствено представителите на зодия Близнаци
10 неповторими черти, които имат единствено представителите на зодия Близнаци  Кои храни би трябвало да заобикаляме, в случай че постоянно ни боли глава? (ВИДЕО)
Кои храни би трябвало да заобикаляме, в случай че постоянно ни боли глава? (ВИДЕО)  Имате ли цип на облеклата? Вижте го деликатно, написа ли YKK? Последни
Имате ли цип на облеклата? Вижте го деликатно, написа ли YKK? Последни  Задържаха 10 лица, злоупотребявали с деца онлайн
Задържаха 10 лица, злоупотребявали с деца онлайн  Това видео шокира Германия: Искаш да зяпаш умрели хора?
Това видео шокира Германия: Искаш да зяпаш умрели хора?  Защо да отглеждаме октоподи във ферми не е добра концепция
Защо да отглеждаме октоподи във ферми не е добра концепция  Книгите, които да прочетем през юни
Книгите, които да прочетем през юни  Гешев съпостави кмета в Пловдив с " Младост "
Гешев съпостави кмета в Пловдив с " Младост "  Колко боровинки би трябвало да похапваме дневно и за какво са...
Колко боровинки би трябвало да похапваме дневно и за какво са...  Големият победител в Hell’s Kitchen е...
Големият победител в Hell’s Kitchen е...  Една легенда на 89г. – Клинт Истууд
Една легенда на 89г. – Клинт Истууд  Тайната на гората в Папуа - плодните прилепи
Тайната на гората в Папуа - плодните прилепи  Ариана Гранде разкрила, че е алергична към доматите
Ариана Гранде разкрила, че е алергична към доматите  Новият Superb ще е по-евтин от предходния модел
Новият Superb ще е по-евтин от предходния модел  Кола блъсна Георги Дюлгеров, водачът избяга
Кола блъсна Георги Дюлгеров, водачът избяга  Новолуние в Близнаци - какво би трябвало да знаем
Новолуние в Близнаци - какво би трябвало да знаем  Азия към този момент не желае боклука на развитите страни
Азия към този момент не желае боклука на развитите страни  В Божурище стачкуват, желаят си кмета
В Божурище стачкуват, желаят си кмета  Опасно време, превалявания и градушки
Опасно време, превалявания и градушки  Задържан е капитанът на кораба, обърнал се в Дунав
Задържан е капитанът на кораба, обърнал се в Дунав  Едни от най-красивите градчета в Чехия (СНИМКИ)
Едни от най-красивите градчета в Чехия (СНИМКИ)  Зукърбърг избави поста си, желае отговорност от...
Зукърбърг избави поста си, желае отговорност от...  Ако вярваш, че един човек може да промени света... Всичко от през днешния ден Виц на деня Наложило се да се прелее кръв на един чужденец, който заречен огромна сума за това. Кръводарителят - габровец... изискал да му се заплати авансово в брой. Лекарите… Прочети целия Обратно в уеб страницата
Ако вярваш, че един човек може да промени света... Всичко от през днешния ден Виц на деня Наложило се да се прелее кръв на един чужденец, който заречен огромна сума за това. Кръводарителят - габровец... изискал да му се заплати авансово в брой. Лекарите… Прочети целия Обратно в уеб страницата
За да пишете, оценявате или докладвате мнения, апелирам логнете се в профила си.
Вход Регистрация Потребителско име* Парола* Запомни ме забравена ключова дума Потребителско име* Полето Потребителско име не би трябвало да е празно. E-mail* Полето E-mail не би трябвало да е празно. Парола* Полето Парола не би трябвало да е празно. Парола (отново)* Полето Повторете паролата не би трябвало да е празно. Име Полето Име не би трябвало да е празно. Дата на раждане Полето Дата на раждане не би трябвало да е празно. Декларирам, че съм се срещнал с Общите условия за прилагане на услугите на Нетинфо. Истории, които споделяте в планина в Южна Африка
в планина в Южна Африка 

 в Йерусалим (СНИМКИ)
в Йерусалим (СНИМКИ) 
 Берлинският магазин с шедьоври от България Водещи вести
Берлинският магазин с шедьоври от България Водещи вести  Опасно време, превалявания и градушки
Опасно време, превалявания и градушки  Гешев съпостави кмета в Пловдив с " Младост "
Гешев съпостави кмета в Пловдив с " Младост " 
 31 май 2019, 12:08 .a{fill:#fff;}.b{fill:#676767;}
31 май 2019, 12:08 .a{fill:#fff;}.b{fill:#676767;} 
Защо да отглеждаме октоподи във ферми не е добра концепция

Книгите, които да прочетем през юни

Колко боровинки би трябвало да похапваме дневно и за какво са потребни

Една легенда на 89г. – Клинт Истууд

Тайната на гората в Папуа - плодните прилепи

Ариана Гранде разкрила, че е алергична към доматите

Новолуние в Близнаци - няколко неща, които би трябвало да знаем

Едни от най-красивите градчета в Чехия (СНИМКИ)
е може да се отхвърли, че развъждането на животни има голямо значение за човечеството от милиони години.
За разлика от овцете и кравите обаче, които са пригодени да бъдат отглеждани от хора, има и типове, които не биха процъфтявали във ферми.
В нов отчет учени коментират за какво октоподите не би трябвало да бъдат отглеждани във ферми.
Не единствено тъй като са интелигентни, само че и поради последствията, до които това ще докара.
Световният апетит за октоподи пораства
През миналата година заради огромното търсене и незадоволителния запас цените на октоподите стремително се повишиха. Експерти чакат те да останат високи най-малко до края на 2019 година
Количеството октоподи, уловени в свободни води, варира, което прави ловците на октоподи несигурни източници на скъпия артикул.
Това кара хората да стартират да отглеждат октоподи във ферми и даже да организират опити да развъждат главоноги мекотели посредством генна трансформация.
Учените се притесняват, че развъждането на октоподи ще докара до неизбежни последици за околната среда като азотно и фосфорно замърсяване от скотски боклуци, кръстосване на типове, разпространение на заболявания и дано не забравяме – загуба на естествения хабитат на октоподите.
По тематиката
 Откриха подводен град на октоподи в Австралия
Откриха подводен град на октоподи в Австралия  Как рибите оцеляват при гръмотевична стихия
Как рибите оцеляват при гръмотевична стихия  Учени предвиждат: до 2048 рибата ще намалее фрапантно
Учени предвиждат: до 2048 рибата ще намалее фрапантно  Колко незнайни на хората същества населяват океаните
Колко незнайни на хората същества населяват океаните Най-притеснително е храненето на октоподите,
пишат учените в отчета си. Както множеството отглеждани във ферми морски животни, октоподите са месоядни. Това значи, че имат потребност от рибен протеин и рибно масло в диетата си.
Недоразвитите октоподи пък се хранят единствено и само с жива храна, която във фермите би трябвало да им се набира непрекъснато.
Една трета от уловената риба по целия свят се употребява за хранене на други животни. Около половината от тази една трета отива при октоподите във фермите.
Много от типовете риби, които хората на драго сърце употребяват, са обект на свръхриболов и броят им фрапантно понижава.
Октоподите имат потребност от доста храна и засищането на глада им може да докара до понижаване на международните ресурси за човечеството.
Дори и този проблем да бъде позволен обаче, има друга аспект, който прави развъждането на типа във ферми неприятна концепция.
Октоподите са известни със своята просветеност
и умеенето си да позволяват проблеми. Поради тази причина в аквариумите им се оставят разнообразни играчки, с цел да не се отегчават.
Могат да отварят буркани, да разграничават хората, да запомнят пъзели, които към този момент са решавали, и даже да избягат от аквариум, в случай че са прекомерно отегчени.
Представете си какво би се случило, в случай че октоподите от една плантация провеждат „ бягство от пандиза “…
В плен октоподите развиват ексцентрично държание
като канибализъм и хранене от личните си пипала.
„ Освен аспектите за биологичното здраве и сигурността, октоподите имат потребност от високи равнища на когнитивна стимулация, включваща проучване, операция и надзор над заобикалящата среда. Интензивните фермерски системи са неизбежно негостоприемни за тези животни “, написа екипът от учени.
Поради тези и други фактори учените по света се пробват изкуствено да развъждат октоподи.
Опитите за развъждането на октоподи
в Мексико през последното десетилетие са много обещаващи.
През 2017 година японска компания за морски храни заяви за сполучливо изкуствено измътени яйца на октопод и показа упованията си до края на идната година да може да предлага октоподи.
„ Надяваме се, че тези варианти ще стартират да се ползват и обществото ще осъзнае сериозните екологични и здравословни проблеми, до които планове като развъждане на октоподи във ферми могат да доведат “.
Какво не знаем за опитите върху животни

Следете ни на всички места и когато и да е с мобилното приложение на Vesti.bg. Можете да го изтеглите от Гугъл Play и AppStore.
За още настоящи вести от Vesti.bg последвайте страницата ни в Instagram.
 Абонирайте се и прочетете първи " Непубликувано " и преглед на деня за 2 мин. АБОНИРАЙ съдебна експертиза Редактор: Деница Георгиева Източник: октопод плантация учени пирода .comments-item{clear:left;}.article-comment-types div{z-index:100;}.answer { margin-left:33px; } Фонетична БДС Изключена
Абонирайте се и прочетете първи " Непубликувано " и преглед на деня за 2 мин. АБОНИРАЙ съдебна експертиза Редактор: Деница Георгиева Източник: октопод плантация учени пирода .comments-item{clear:left;}.article-comment-types div{z-index:100;}.answer { margin-left:33px; } Фонетична БДС Изключена * Моля, коментирайте съответната публикация и използвайте кирилица! Не се толерират отзиви с обидно или нецензурно наличие, на верска или етническа основа, както и написани единствено с основни букви!
0 коментара Не пропускай

Далай Лама: Русия би трябвало да влезе в Европейски Съюз

Валери Симеонов: В ГЕРБ оставките са насилствени

Зов за помощ: Да помогнем на Калина да живее

Класираха измежду колите втора употреба
За дома

 Апартамент в Пловдив, който очарова с интериор (СНИМКИ)
Апартамент в Пловдив, който очарова с интериор (СНИМКИ)  Една причина за какво би трябвало да имате свежи цветя в дома.box-CashCredit { margin: 50px 0; }.box-CashCredit img { width: 100%; height: auto; }.box-CashCredit.list-item:nth-child(1) { border-top: 0 none; }.box-CashCredit.box-content { border: 9px solid #316fa0; }
Една причина за какво би трябвало да имате свежи цветя в дома.box-CashCredit { margin: 50px 0; }.box-CashCredit img { width: 100%; height: auto; }.box-CashCredit.list-item:nth-child(1) { border-top: 0 none; }.box-CashCredit.box-content { border: 9px solid #316fa0; }  Горите, в които е по-добре да не стъпва човешки крайник (ВИДЕО)
Горите, в които е по-добре да не стъпва човешки крайник (ВИДЕО)  10 неповторими черти, които имат единствено представителите на зодия Близнаци
10 неповторими черти, които имат единствено представителите на зодия Близнаци  Кои храни би трябвало да заобикаляме, в случай че постоянно ни боли глава? (ВИДЕО)
Кои храни би трябвало да заобикаляме, в случай че постоянно ни боли глава? (ВИДЕО)  Имате ли цип на облеклата? Вижте го деликатно, написа ли YKK? --> АКЦЕНТИ
Имате ли цип на облеклата? Вижте го деликатно, написа ли YKK? --> АКЦЕНТИ  Горите, в които е по-добре да не стъпва човешки крайник (ВИДЕО)
Горите, в които е по-добре да не стъпва човешки крайник (ВИДЕО)  10 неповторими черти, които имат единствено представителите на зодия Близнаци
10 неповторими черти, които имат единствено представителите на зодия Близнаци  Кои храни би трябвало да заобикаляме, в случай че постоянно ни боли глава? (ВИДЕО)
Кои храни би трябвало да заобикаляме, в случай че постоянно ни боли глава? (ВИДЕО)  Имате ли цип на облеклата? Вижте го деликатно, написа ли YKK? Последни
Имате ли цип на облеклата? Вижте го деликатно, написа ли YKK? Последни  Задържаха 10 лица, злоупотребявали с деца онлайн
Задържаха 10 лица, злоупотребявали с деца онлайн  Това видео шокира Германия: Искаш да зяпаш умрели хора?
Това видео шокира Германия: Искаш да зяпаш умрели хора?  Защо да отглеждаме октоподи във ферми не е добра концепция
Защо да отглеждаме октоподи във ферми не е добра концепция  Книгите, които да прочетем през юни
Книгите, които да прочетем през юни  Гешев съпостави кмета в Пловдив с " Младост "
Гешев съпостави кмета в Пловдив с " Младост "  Колко боровинки би трябвало да похапваме дневно и за какво са...
Колко боровинки би трябвало да похапваме дневно и за какво са...  Големият победител в Hell’s Kitchen е...
Големият победител в Hell’s Kitchen е...  Една легенда на 89г. – Клинт Истууд
Една легенда на 89г. – Клинт Истууд  Тайната на гората в Папуа - плодните прилепи
Тайната на гората в Папуа - плодните прилепи  Ариана Гранде разкрила, че е алергична към доматите
Ариана Гранде разкрила, че е алергична към доматите  Новият Superb ще е по-евтин от предходния модел
Новият Superb ще е по-евтин от предходния модел  Кола блъсна Георги Дюлгеров, водачът избяга
Кола блъсна Георги Дюлгеров, водачът избяга  Новолуние в Близнаци - какво би трябвало да знаем
Новолуние в Близнаци - какво би трябвало да знаем  Азия към този момент не желае боклука на развитите страни
Азия към този момент не желае боклука на развитите страни  В Божурище стачкуват, желаят си кмета
В Божурище стачкуват, желаят си кмета  Опасно време, превалявания и градушки
Опасно време, превалявания и градушки  Задържан е капитанът на кораба, обърнал се в Дунав
Задържан е капитанът на кораба, обърнал се в Дунав  Едни от най-красивите градчета в Чехия (СНИМКИ)
Едни от най-красивите градчета в Чехия (СНИМКИ)  Зукърбърг избави поста си, желае отговорност от...
Зукърбърг избави поста си, желае отговорност от...  Ако вярваш, че един човек може да промени света... Всичко от през днешния ден Виц на деня Наложило се да се прелее кръв на един чужденец, който заречен огромна сума за това. Кръводарителят - габровец... изискал да му се заплати авансово в брой. Лекарите… Прочети целия Обратно в уеб страницата
Ако вярваш, че един човек може да промени света... Всичко от през днешния ден Виц на деня Наложило се да се прелее кръв на един чужденец, който заречен огромна сума за това. Кръводарителят - габровец... изискал да му се заплати авансово в брой. Лекарите… Прочети целия Обратно в уеб страницата За да пишете, оценявате или докладвате мнения, апелирам логнете се в профила си.
Вход Регистрация Потребителско име* Парола* Запомни ме забравена ключова дума Потребителско име* Полето Потребителско име не би трябвало да е празно. E-mail* Полето E-mail не би трябвало да е празно. Парола* Полето Парола не би трябвало да е празно. Парола (отново)* Полето Повторете паролата не би трябвало да е празно. Име Полето Име не би трябвало да е празно. Дата на раждане Полето Дата на раждане не би трябвало да е празно. Декларирам, че съм се срещнал с Общите условия за прилагане на услугите на Нетинфо. Истории, които споделяте
 в планина в Южна Африка
в планина в Южна Африка 

 в Йерусалим (СНИМКИ)
в Йерусалим (СНИМКИ) 
 Берлинският магазин с шедьоври от България Водещи вести
Берлинският магазин с шедьоври от България Водещи вести  Опасно време, превалявания и градушки
Опасно време, превалявания и градушки  Гешев съпостави кмета в Пловдив с " Младост "
Гешев съпостави кмета в Пловдив с " Младост " 
Източник: vesti.bg

КОМЕНТАРИ





